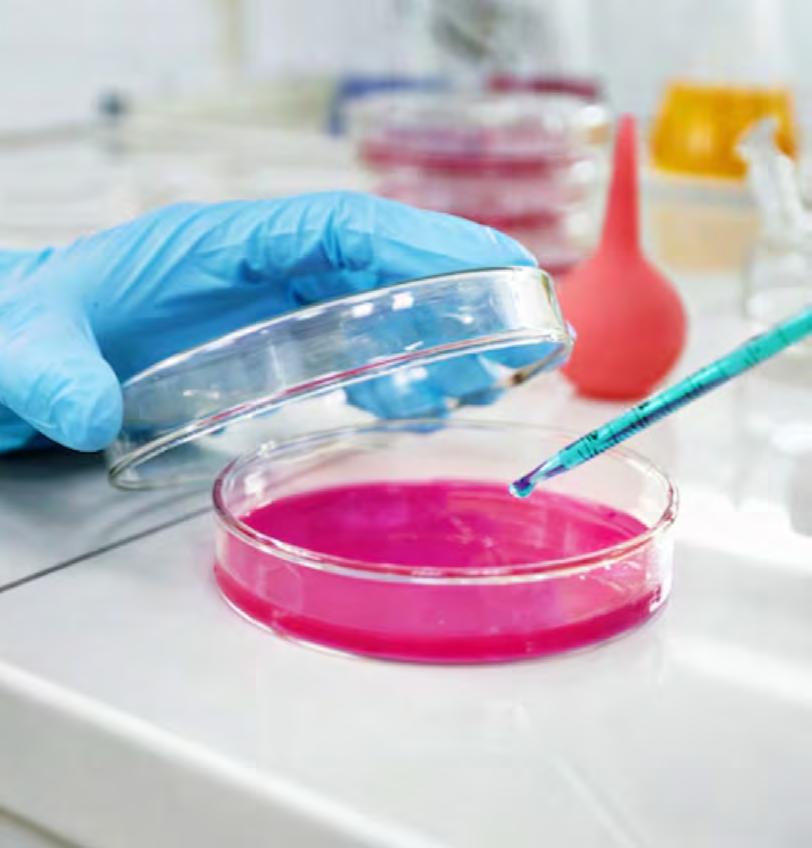

Mecánico fue condenado a 20 años de cárcel por violar a las hijas de su pareja

Justicia negó sobreseimiento a exjuez acusado de grabar a mujeres en gimnasio

“Zúmbale Primo” se subirá por tercera vez al escenario de la “Expo Quillota”


![]()

Justicia negó sobreseimiento a exjuez acusado de grabar a mujeres en gimnasio

“Zúmbale Primo” se subirá por tercera vez al escenario de la “Expo Quillota”


Una camioneta y dos motocicletas se suman a la flota municipal gracias a recursos de la
Subsecretaría de Prevención del Delito
E n el marco del proyecto “Más Seguridad para La Cruz: Patrullajes Preventivos”, la Municipalidad de La Cruz presentó la incorporación de una camioneta Toyota Hilux y dos motocicletas Vogue 300rally, vehículos que reforzarán la labor de patrullaje en la comuna. La entrega se concretó gracias a un financiamiento de 50 millones de pesos provenientes de la Subsecretaría de Prevención del Delito.
L a ceremonia contó con la presencia de la alcaldesa Filomena Navia Hevia, la jefa de la División de Desarrollo Territorial de la Subsecretaría de Prevención del Delito, Fernanda Vicencio, y la profesional
del mismo organismo, Daniela Parada.
S egún explicó la jefa comunal, la llegada de estos vehículos permitirá ampliar la cobertura y mejorar la capacidad de respuesta en situaciones de riesgo, especialmente en sectores rurales, escolares y comunitarios. “Hoy estamos felices porque tenemos estas motos y esta camioneta que hemos logrado a través de los recursos de la Subsecretaría de Prevención del Delito. Son 50 millones de pesos que nos han llegado acá a la comuna de La Cruz, gracias al trabajo que estamos haciendo con nuestra Dirección de Seguridad, con la Subsecretaría y con el apoyo de
la comunidad. Estas máquinas totalmente habilitadas van a recorrer desde ahora en adelante nuestra comuna velando por la seguridad de todos nuestros habitantes”, señaló la alcaldesa Filomena Navia.
Por su parte, Fernanda Vicencio destacó la importancia del trabajo municipal en la prevención: “Para nosotros es muy importante ver cómo los municipios desarrollan distintos proyectos a través de nuestro programa Sistema Nacional de Seguridad Municipal, que entrega recursos a todo el país. Hoy estamos en La Cruz inaugurando la entrega de una camioneta y de dos motos que significan poder fortalecer y robustecer el trabajo que realiza el municipio y llegar a localidades mucho más rurales de forma rápida y oportuna”.

Con esta nueva flota, el municipio de La Cruz reafirma su compromiso de garantizar mayor tranquilidad a las familias, reforzando la prevención y patrullajes preventivos en toda la comuna.
El tribunal acreditó que el acusado cometió los ilícitos aprovechando los momentos en que quedaba a su cuidado
El Tribunal de Juicio Oral en lo Penal de Quillota condenó a 20 años de presidio mayor en su grado máximo a un hombre de 33 años, mecánico y conductor de camión, declarado culpable de cometer reiterados delitos de violación y abuso sexual en contra de las hijas menores de edad de su pareja, entre 2017 y 2023
S egún acreditó la investigación de la Fiscalía Local de Quillota, los ilícitos se producían cuando el acusado quedaba al cuidado de las niñas, aprovechando su posición de confianza. Durante el juicio, el hombre decidió declarar y reconoció los hechos: “Quiero partir reconociendo todos los hechos que se me están acusando, pedir las disculpas, es algo que nunca debí haber hecho”, afirmó.
La sentencia fue dictada tras la valoración de pruebas testimoniales, periciales y documentales presentadas por el Ministerio Público. El tribunal calificó los hechos como constitutivos de dos delitos reiterados de abuso sexual y dos delitos reiterados de violación de menores de 14 años, todos consumados.
L a fiscal especializada en delitos sexuales de Quillota, Gabriela Fuenzalida, destacó el fallo y su importancia: “Esta condena de 20 años efectivos refleja la gravedad de los hechos acreditados, el daño causado a las víctimas y la respuesta firme de la justicia
frente a delitos que vulneran lo más íntimo y sagrado de niñas y niños. Como Fiscalía, seguiremos trabajando para que
quienes cometan estos crímenes reciban penas ejemplares y las víctimas obtengan justicia”. L a pena deberá cumplirse de manera efectiva, descontando únicamente el período en que el condenado estuvo en prisión preventiva tras su formalización.


La investigación se inició tras el hallazgo de un cuerpo en Hualpén, que permitió desarticular a una red de usureros colombianos que operaba en diversas zonas del país
U n amplio operativo del OS9 de Carabineros, desarrollado en cinco regiones del país, culminó con la detención de 15 ciudadanos colombianos vinculados a delitos de usura, lavado de activos, extorsión y asociación criminal.
La investigación se remonta a más de un año, cuando fue encontrado el cuerpo de un hombre al interior de un vehículo en el camino a Caleta Chome, comuna de Hualpén. En esa ocasión, un teléfono celular incautado permitió dar con anteceden-
tes de una red de prestamistas conocida por la modalidad de préstamos “gota a gota”, caracterizados por altos intereses y métodos violentos de cobro.
Las diligencias permitieron identificar a los integrantes de la organización, que operaba en las regiones de Valparaíso, O’Higgins, Bío Bío, Los Ríos y Los Lagos. En los allanamientos, Carabineros incautó computadores, teléfonos celulares, vehículos, motocicletas y una importante suma de dinero en efectivo.
S egún información preli -

minar a la que accedió Radio Biobio, los detenidos serán puestos a disposición del Juzgado de Garantía de Concepción este jueves, audiencia en la que algunos imputados podrían comparecer de manera remota.

Tras el rechazo a su solicitud de sobreseimiento, el exmagistrado Alonso Arancibia volvió a ofrecer disculpas a las víctimas y reconoció las consecuencias de sus actos.
El exjuez Alonso Arancibia, acusado de grabar y fotografiar sin autorización a mujeres en un gimnasio de Concón, emitió un escrito en el que reiteró sus disculpas públicas a las víctimas por lo que calificó como su “inexcusable proceder”.
E l documento se conoció luego de que el tribunal rechazara la solicitud de sobreseimiento presentada por su defensa y re-
agendara para el próximo 29 de octubre la audiencia de preparación de juicio oral.
“El tiempo y las circunstancias me han hecho entender y empatizar con el daño causado a las víctimas, el que he tratado de reparar a través de alguna salida alternativa que diera algún tipo de reparación a las afectadas, lo que no prosperó por razones no imputables a

esta parte”, señaló Arancibia. El exmagistrado también se refirió a las consecuencias personales y profesionales de su actuar: “No me queda más que reiterar mi arrepentimiento y ofrecer mis más sinceras disculpas a cada una de las ofendidas, así como a su entorno familiar y social”.
De acuerdo con la Fiscalía, los hechos ocurrieron entre diciembre de 2023 y enero de 2024 en el gimnasio Sportlife del sector Bosques de Montemar, en Concón.
D urante ese periodo, Arancibia registró más de 100 archivos audiovisuales en su teléfono personal, afectando a cuatro mujeres que se ejercitaban en el recinto. El exjuez enfrenta cargos por el registro y difusión de imágenes íntimas sin autorización.
“Sé que para ellas no será fácil dar vuelta la página de este triste episodio vital, pero sinceramente espero que el tiempo logre mitigar en algo las consecuencias causadas por mi proceder”, cerró el exmagistrado en su declaración.
La audiencia de preparación de juicio oral quedó fijada para el 29 de octubre.






El conjunto habitacional Lomas del Sol considera departamentos, casas y sedes sociales, con una inversión superior a los 11 mil millones de pesos
L a comuna de Quillota dio un nuevo paso en materia habitacional con la entrega de 249 viviendas correspondientes al proyecto Lomas del Sol, impulsado por el Ministerio de Vivienda y Urbanismo (Minvu) a través del Fondo Solidario DS49. La iniciativa, que contó con una inversión que supera los 11 mil millones de pesos, forma parte del Plan de Emergencia Habitacional del Gobierno y contempla departamentos, casas de un piso, sedes sociales, estacionamientos y áreas verdes
La seremi de Minvu en Valparaíso, Belén Paredes, destacó que el plan avanza en todas las comunas de la región: “La vivienda definitiva es posible en las treinta y ocho comunas de la región de Valparaíso; llevamos más de 21 mil viviendas y pronto vamos a llegar a las 22 mil. En Quillota vemos cómo la capital provincial se pone
al frente con este proyecto tan esperado”
En tanto, la directora (s) de Serviu Valparaíso, Nerina Paz, explicó que el estándar de las viviendas responde a criterios de mayor calidad: “El metraje de estos hogares va entre 58 y 60 metros cuadrados. Incorporamos diversidad de tipologías y un mejor confort térmico gracias a la envolvente en cada departamento”
El alcalde de Quillota, Luis Mella, resaltó la importancia del proyecto para las familias: “Estamos felices porque
así se construye bienestar y felicidad. La oportunidad de tener la vivienda propia es maravillosa, se construye familia, un hogar y se mejoran las condiciones de vida”
P or su parte, Ana Rosa Guerrero, presidenta del comité habitacional, valoró el esfuerzo colectivo: “Estamos contentos por todas las familias que ya no tendrán que pagar arriendo ni vivir hacinadas. Ahora podrán invertir en salud, educación y en su propio bienestar”.
El conjunto Lomas del Sol está emplazado en un 83,21 % en zona urbana y 16,79 % en zona rural, favoreciendo la interconexión de la comuna
La iniciativa contó con una inversión que supera los 11 mil millones de pesos.



Quillota contará con nuevos baños permanentes en el recinto, que estará abierto para las celebraciones de Fiestas Patrias y tendrá un plan de recuperación total en los próximos años
Este miércoles 10 de septiembre se firmó un acuerdo tripartito entre la Municipalidad de Quillota, la empresa Aguas Pacífico y la mesa territorial Boco Crece Unido, con el objetivo de recuperar el Parque El Edén. El convenio permitió la instalación de tres contenedores que suman 15 baños con lavamanos, tres urinarios y un baño universal, los que quedarán de forma permanente en el recinto.
L a infraestructura fue inaugurada oficialmente en la misma jornada, justo a tiempo para recibir a las familias que asistirán a las celebraciones de Fiestas Patrias. El parque abrirá sus puertas entre el miércoles 17 y el domingo 21 de septiembre, con entrada liberada para quienes deseen disfrutar de asados y actividades al aire libre. A los 15 baños instalados se sumarán otros arrendados por el munici-

pio para reforzar el servicio. El convenio fue suscrito por el alcalde de Quillota, Luis Mella; el gerente de Asuntos Corporativos y Desarrollo Social de Aguas Pacífico, Javier Celedón; y la presidenta de la mesa territorial Boco Crece Unido, María Elena Arancibia.
Durante la ceremonia, el alcalde Mella recalcó que esta alianza es el primer paso para la reapertura total de El Edén. El jefe comunal adelantó que
ya gestionan permisos para que adultos mayores y colegios puedan realizar sus fiestas de fin de año en el recinto. Además, proyectan actividades en Año Nuevo y en verano, mientras avanzan los estudios técnicos y ambientales que requiere la recuperación integral del parque.
Según Mella, la recuperación total de El Edén podría concretarse en un plazo de cuatro años. “Esto no se resuelve en uno o dos años, porque debemos cumplir con evaluaciones de impacto ambiental. Pero si sumamos fondos públicos y privados, podremos reabrir las más de 30 hectáreas del parque, con restoranes, cabañas y alojamiento”, explicó.

De esta manera, Quillota avanza en el rescate de uno de sus espacios más emblemáticos, que vuelve a abrir sus puertas a la comunidad tras años de cierre y restricciones.

La normativa también sanciona pegatinas en muros y contempla penas accesorias como labores de limpieza
E l Concejo Municipal de Quilpué aprobó por unanimidad una ordenanza que busca erradicar rayados y pegatinas en la comuna, estableciendo multas de hasta 5 UTM para quienes realicen pintadas en muros o fachadas de bienes públicos o privados sin autorización. En caso de reincidencia, la sanción podrá duplicarse.
La normativa también contempla sanciones de hasta 3 UTM para quienes instalen pegatinas
en muros y fachadas, igualmente duplicables si se repite la falta. Además, serán responsables las empresas, marcas, artistas u organizadores mencionados en los rayados o afiches.
El Juez de Policía Local podrá sumar labores de limpieza, pintado o hermoseamiento como pena accesoria. En caso de que el infractor sea menor de edad, las multas o reparaciones recaerán en los padres o adultos responsables.


Esta ordenanza se enmarca en el programa municipal “Recuperando Quilpué”, iniciativa que busca recuperar espacios públicos y promover la colaboración público-privada. A través de este plan, empresas como Easy, Tricolor y Hela pintaron recientemente la fachada de 41 locales en el centro de la ciudad. Asimismo, en conjunto con Gendarmería, se intervinieron los pasos bajo nivel peatonales. La alcaldesa Carolina Corti destacó que esta medida refuerza el ordenamiento territorial y la seguridad pública: “La Municipalidad de Quilpué junto al Honorable Concejo ha aprobado por unanimidad la ordenanza que multa en 5 UTM a quienes rayen la ciudad. Se prohíben rayados y pegatinas en bienes nacionales de uso público y propiedad privada. Esto busca cerrar un conjunto de acciones de seguridad pública y hermoseamiento del entorno, además del esfuerzo de privados por mantener fachadas limpias”.
Como medida adicional, se informó que los establecimientos que mantengan sus fachadas libres de rayados podrán acceder a rebajas en sus pagos municipales: un 10% en el derecho anual de publicidad y un 5% en derechos de aseo para quienes no estén afectos a ese pago, siempre que cumplan con las condiciones de la normativa.
Operativo del OS7 y GOPE permitió incautar más de cinco mil dosis de pasta base, marihuana, cocaína, armas y vehículos en la Villa 250 Años
U n amplio operativo policial encabezado por Carabineros del OS7 Aconcagua, con apoyo del GOPE Valparaíso y la Sección Centauro Aconcagua, culminó con la detención de tres personas y la incautación de drogas, armas y diversos elementos asociados al delito de tráfico.
L a diligencia, realizada en coordinación con la Fiscalía Local de San Felipe, se concretó tras órdenes de entrada y registro a tres domicilios ubicados en la Villa 250 Años.
E n el procedimiento, los equipos especializados lograron incautar 5.058 dosis de pasta base de cocaína, clorhidrato de cocaína y marihuana elaborada, además
de una pistola a fogueo, munición, dos vehículos, dinero en efectivo, balanzas digitales y otros elementos vinculados
a la venta de drogas.
C omo resultado, fueron detenidos un hombre de 50 años y dos mujeres de 20 y 32, todos con antecedentes penales. Los imputados quedaron a disposición de la justicia y serán formalizados en la jornada de hoy en el Tribunal de Garantía de San Felipe.

Tres domicilios en la Villa 250 Años fueron allanados en el operativo.

Autoridades locales confirmaron refuerzos de Carabineros, patrullajes municipales, controles vehiculares y guardias privados para resguardar a los asistentes al evento dieciochero más masivo de Quillota
Con un fuerte énfasis en la seguridad, este lunes 8 de septiembre se presentó el plan oficial para las celebraciones de Fiestas Patrias que se desarrollarán en el Parque Ludiano y la Casona Boco, entre el 17 y el 21 de septiembre, en horario de 13:00 a 04:00 horas.
E l evento, catalogado como la “Ramada Oficial” de Quillota, espera una masiva asistencia de público, por lo que autoridades y organizadores confirmaron distintas medidas de resguardo.
El mayor Julio Ramos, jefe de la 4ª Comisaría de Quillota, confirmó que Carabineros dispondrá de un servicio especial durante todas las jornadas, reforzado con patrullajes preventivos municipales.
A demás, la Dirección de Seguridad Pública detalló que se implementarán controles vehiculares y que el recinto contará con hasta 25 guardias privados distribuidos en los distintos sectores.
Para facilitar el acceso de los visitantes, la organización habilitará 2 mil estacionamientos, cuyo valor será de $5.000 por vehículo.
Con estas medidas, la Municipalidad de Quillota busca que la tradicional celebración dieciochera en la Casona Boco se desarrolle en un ambiente seguro, ordenado y familiar, potenciando así una de las actividades más concurridas de la provincia durante las Fiestas Patrias.

El evento se desarrollará entre el 30 de octubre y el 2 de noviembre en el Estadio Lucio Fariña Fernández, con artistas nacionales e internacionales, además de destacados humoristas
La parrilla de la Expo Quillota 2025 sigue tomando forma. Durante su visita a Radio Quillota 101.5 FM, el alcalde Luis Mella confirmó que la jornada del sábado 1 de noviembre tendrá un fuerte sello bailable con la presentación de Zúmbale Primo y Los Pincheira del Sur, mientras que el humor estará a cargo de la reconocida dupla Cebolla y Bodoque. El anuncio se suma a los nom-
bres ya confirmados la semana pasada, cuando el jefe comunal adelantó que la noche inaugural del 30 de octubre contará con la presencia de José Luis “El Puma” Rodríguez y Américo, además de la rutina humorística de Mauricio Palma con su personaje “Violento Parra”. El edil también recalcó que el viernes 31 de octubre estará dedicado a la música urbana, mientras que el cierre del do -
mingo 2 de noviembre traerá a un invitado internacional, cuyas identidades aún no se han revelado.
De esta forma, la Expo Quillota 2025 se prepara para recibir a miles de asistentes en cuatro jornadas que combinarán música, humor y entretenimiento en el Estadio Lucio Fariña Fernández, reafirmando su posición como uno de los eventos más esperados de la provincia.

Un choque entre una camioneta y un automóvil dejó a una persona lesionada y generó atochamientos en uno de los accesos más importantes a la Ruta 5 Norte
Una fuerte congestión vehicular se registró esta mañana en el sector del enlace El Olivo, en Hijuelas, luego de un accidente de tránsito que involucró a dos vehículos menores y que dejó a una persona lesionada.
E l hecho ocurrió cerca de las 9:00 horas de este miércoles, cuando una camioneta y un automóvil colisionaron en esta estratégica conexión de la Ruta 5 Norte, lo que obligó a la rápida concurrencia de equipos de emergencia de la comuna.
De acuerdo con la información preliminar, solo una persona resultó con lesiones menores, siendo atendida en primera instancia por personal de salud de Hijuelas y posteriormente tras-
ladada al Hospital de La Calera. El accidente generó importantes dificultades al tránsito en dirección hacia La Calera,
con largas filas de vehículos a la espera de poder avanzar. Tras poco más de una hora de trabajo en la zona, las pistas fueron despejadas y el flujo vehicular se normalizó.

Solo una persona resultó lesionada en el accidente.

Una colisión entre un vehículo menor y un camión betonero en el kilómetro 20 de la Ruta 60CH terminó con una conductora de 39 años con lesiones de mediana gravedad
D urante la mañana de este miércoles, alrededor de las 10:30 horas, se registró un accidente de tránsito en el kilómetro 20 de la Autopista 60CH, a la altura del paradero 6 en la comuna de San Pedro.
E l hecho involucró a un automóvil particular que impactó contra un camión betonero que permanecía detenido en la pista de emergencia. Producto de la colisión, el vehículo menor terminó volcado, resultando lesionada su conductora, una mujer de 39 años, quien fue trasladada con diagnóstico de mediana gravedad.
E l profesional de turno de Gestión de Riesgos, Franco Olivares Carrasco, entregó detalles preliminares: “En el lugar trabajó personal de Bomberos de Quillota, dos unidades de apoyo médico de la autopista, Carabineros y el equipo de Gestión de Riesgos y Desastres. La emergencia obligó a mantener interrumpida la pista lenta en dirección hacia Viña del Mar durante el operativo”.
El accidente está siendo investigado por Carabineros de la Tenencia Las Cruzadas de San Pedro, mientras que los equipos del COGRID comunal participaron en la coordinación de la respuesta.






10 de septiembre 2025

Fíjense que hay un dicho que dice que siempre valoramos más, lo que perdemos y si hablamos de las carreteras, es muy cierto. Desde las alturas las apreciamos más, y hacen que podamos movernos entre ciudades con mucha agilidad.
¿Descentralización
Francisca Undurraga
Investigadora
En Chile, el delito se manifiesta de maneras muy diversas según las particularidades del territorio. Así lo demuestran los violentos “turbazos” en las comunas periféricas de los grandes centros urbanos, como Colina y San Bernardo; la concentración del tráfico ilegal de vehículos en las zonas fronterizas del norte, y el aumento sostenido de los delitos asociados a drogas en las ciudades portuarias de Valparaíso y San Antonio.
Este escenario heterogéneo, evidencia que buena parte de los problemas de seguridad persisten, justamente, por la escasa capacidad del Estado para adaptar sus políticas a las realidades locales, pasando por alto aspectos tan relevantes como la geografía, la fragmentación urbana y las actividades productivas de cada sector. De ahí la urgencia por retomar una conversación difícil, poco atendida en su real magnitud y dejada cómodamente a la deriva en las últimas discusiones sobre seguridad: ¿cómo asegurar una gobernanza que responda a las particularidades territoriales?
Frente a esta interrogante, autores como Ojeda y Acero, y organismos como la CEPAL, plantean que la descentralización podría ser una respuesta prometedora para mejorar la pertinencia y la eficacia de las políticas públicas en seguridad, sustentando sus propuestas en algunos lineamientos determinantes para su éxito:
En primer lugar, se recomienda una estructura multinivel que articule de manera clara y efectiva a las distintas autoridades. En ella, el nivel central debe permitir que las autoridades locales asuman un rol vinculante en la implementación de las políticas nacionales, aportando tanto en el diagnóstico como en las decisiones que afectan directamente a sus territorios. En segundo lugar, se debe priorizar una desconcentración administrativa por sobre una descentralización total, trasladando funciones operativas a los niveles subnacionales y asegurando la profesionalización gradual de los equipos locales. Esto permitiría mayores capacidades técnicas en terreno y una mejor comprensión estatal de los problemas específicos de cada zona. Por último, se debe contar con sistemas efectivos de control y rendición de cuentas, que garanticen
de Fundación P!ensa

la transparencia interinstitucional y permitan una medición periódica de las intervenciones.
Los cambios experimentados por Medellín a inicios de siglo ofrecen un ejemplo exitoso de algunas de estas ideas. Mientras desde el nivel central se procuraron estándares de coordinación y metas de priorización territorial, la alcaldía lideró un plan trabajado en conjunto con la policía, la fiscalía y los servicios de justicia para asegurar presencia continua en los barrios. Este trabajo se apoyó en la ampliación de los equipos técnicos municipales y en instancias de monitoreo periódico, que permitieron mejoras sostenidas en seguridad y una reducción de los homicidios en un 67% en un rango de dos años.
Sin embargo, como todo proceso que tensiona el modelo de gobernanza, la descentralización no está exenta de riesgos. El reciente caso del robo con homicidio de Michael Peñaloza en Curacaví, donde el alcalde se involucró directamente en la entrega de uno de los imputados, actuando fuera de sus competencias y pasando por sobre Carabineros y Fiscalía, ilustra precisamente algunos de los peligros de nuestra situación actual. Más allá de cualquier debate sobre intenciones, el caso refleja cómo algunas autoridades locales, al ser presionadas por la ciudadanía en un contexto de crisis, pueden verse inclinadas a exceder las competencias ya definidas por ley, lo que configura un escenario poco propicio para una discusión sobre la expansión de las competencias locales.
En estos meses previos a las elecciones, abrir la discusión sobre las estrategias que permitirán enfrentar el delito a nivel territorial se ha vuelto una necesidad ineludible, especialmente cuando el crimen organizado ya aprovecha estas “ventajas comparativas” para expandirse evadiendo el control estatal. Repensar instancias como los Consejos Comunales y Regionales de Seguridad, impulsar acuerdos vinculantes entre las instituciones del Estado a nivel local y financiar unidades de análisis dependientes del nuevo Ministerio de Seguridad en cada municipio, son algunas propuestas que podrían ser viables para el caso chileno. Por el contrario, posponer esta conversación significará seguir fallándole a las personas a lo largo del país.
PÁRRAFO DESTACADO
MIRARSE EL OMBLIGO
“El problema central de la derecha, a mi juicio, es generar las condiciones para contar con algo así como una mayoría políticamente operativa. Si gana Kast, necesitará a Matthei y ChileVamos; y, si gana Matthei, necesitará a Kast y republicanos. Ese es el dato fundamental que, me temo, muchos olvidan al fragor de la campaña. Mirarse el ombligo no le sirve a nadie, me parece”.
Daniel Mansuy, académico de la U. de los Andes (Ex Ante, 4 de septiembre 2025)
EMPRESA PERIODÍSTICA EL OBSERVADOR
“La Verdad más que un valor es una actitud ante la vida”
Roberto Silva Bijit
Fundador y Presidente del Directorio:
Roberto Silva Bijit
Director:
Roberto Silva Binvignat
Jefe de Informaciones: Gabriel Abarca Armijo
La Concepción 277 - Quillota www.observador.cl
Coordinadora Comercial:
Verónica Tapia Herrera ventasquillota@observador.cl
Fono: +56 9 8887 9747Casa Matriz - Quillota

“Tiene que ser con un rango”
El legado científico de Chile: la protección de los cielos oscuros
Cuando se acerca el fi n de un periodo de gobierno, siempre surge la necesidad de resaltar un legado que perpetúe la labor realizada durante la administración. En este contexto, el actual gobierno aún tiene la posibilidad de consolidar el valor de la ciencia y la sostenibilidad como ejes estratégicos para nuestro crecimiento.
C hile cuenta con condiciones naturales únicas para el desarrollo astronómico. Junto a ello, desde hace más de medio siglo el país ha implementado una política de Estado transversal que ha atraído importantes inversiones internacionales y que nos ha consolidado como la capital mundial de la astronomía.
Gracias a esa visión hoy se
desarrollan investigaciones de frontera que contribuyen al conocimiento universal. Sin embargo, el avance de la contaminación lumínica amenaza nuestros cielos nocturnos, un patrimonio científico, medioambiental y cultural crucial.
Proteger los cielos oscuros significa perpetuar un recurso natural irremplazable y apostar por un desarrollo productivo basado en la ciencia, la innovación, el turismo astronómico y la educación. El Presidente Boric tiene en sus manos la oportunidad única de fortalecer esta política de Estado y dejar una herencia que trascienda generaciones y fronteras: la protección de nuestros cielos oscuros como un legado de Chile hacia el mundo.
Daniela González Directora Ejecutiva Fundación Cielos de Chile
Camila Vallejo Ministra de la Segegob
“En nuestra mirada tiene que ser con un rango considerando el costo de la vida que tienen las personas en el país y las multas tienen que ser proporcionales a cómo enfrentan el día a día nuestros compatriotas. No ha sido fácil y como ustedes saben el desafío, para el Ejecutivo, siempre es poder cuadrar el círculo en estas materias”.
(El Mercurio, 7 de septiembre 2025)

“Es el momento de dar certezas”
Joanna Pérez Diputada Demócratas
“Ya se dio una especie de marcha blanca, pero ahora se debe hacer con un desde y un hasta; acerca de la ley permanente, es el momento de dejarla de ese modo y dar certezas, no improvisando para cada elección. Se debe legislar de manera permanente, porque después somos los mismos incumbentes los que definimos y algunos sacan cuentas de lo que más les conviene”.
(El Mercurio, 7 de septiembre 2025)
El delantero canario deberá estar cerca de dos meses fuera de las canchas tras sufrir una lesión en el partido contra Santiago Wanderers
San Luis de Quillota recibió un duro golpe en medio de la temporada. El delantero Martín Carreño deberá ser sometido a cirugía tras confirmarse una rotura de menisco, lesión sufrida en el partido disputado el pasado sábado frente a Santiago Wanderers.
De acuerdo con el informe médico entregado por el club, el atacante se sometió a exámenes que determinaron la necesidad de una intervención quirúrgica. La operación está programada para la tarde de este miércoles en una clínica de Santiago.
El período de recuperación estimado es de dos meses, lo que deja al equipo “canario” sin una de sus principales cartas ofensivas. Carreño, quien venía consolidándose como uno de los goleadores de la temporada, deberá enfocarse en la rehabilitación para retomar su nivel lo antes posible.
El cuerpo técnico encabezado por el director técnico ajustará las estrategias ofensivas mientras dure la ausencia del delantero, a la espera de su evolución postoperatoria.
Desde el club señalaron que el proceso de rehabilitación de Carreño comenzará de inmediato tras la cirugía, con el objetivo de acelerar su retorno a las canchas y volver a ser una pieza clave en la ofensiva amarilla.
La cirugía de Martín Carre
ño está programada para este miércoles en Santiago.

El equipo Sub 14 enfrenta esta tarde a Biobío por la medalla de oro. En damas, el Colegio Curimón disputará el bronce ante el mismo rival
San Felipe vive un momento histórico en el deporte escolar. El equipo masculino de vóleibol del Sunnyland School alcanzó la final nacional de los Juegos Deportivos Escolares 2025 en la categoría Sub 14, y esta tarde irá por la medalla de oro frente al representante de la Región del Biobío.
Los sanfelipeños avanzaron a cuartos de final de manera invicta, instancia en la que derrotaron por un contundente 3-0 al elenco de O’Higgins. Luego, en semifinales, protagonizaron un emocionante

partido frente a la Región Metropolitana, imponiéndose por 3-2 y asegurando su lugar en la definición por el título.
M ientras tanto, en la serie

femenina, el Colegio Curimón también ha dejado en alto el nombre de San Felipe. Tras una destacada fase de grupos, superaron en cuartos de final a O’Higgins por 3-1, pero en semifinales cayeron 3-1 ante Coquimbo. Pese a la derrota, el conjunto femenino aún tiene chances de medalla: esta tarde disputarán el bronce frente al equipo de Biobío, en el Centro de Entrenamiento Olímpico de Santiago. La jornada, por lo tanto, será clave para el deporte escolar de la provincia de San Felipe, con dos equipos locales peleando por subirse al podio nacional en la disciplina del vóleibol.
Dos elencos sanfelipeños aún buscan medalla en el voleibol de los Juegos Deportivos Escolares.

Animará la competencia gastronómica más importante de Chile, la ‘Copa Culinaria Carozzi’, que este 2025 cumple 10 años
La conductora también estará junto al chef francés Yann Yvin, quienes conducirán esta versión

de aniversario del evento.
La competencia buscará a los mejores cocineros de Chile, y para eso recorrerán gran parte
tas partes del país, que dejaron huella en las pasadas competencias del evento.
E l objetivo de esta edición aniversario será encontrar al mejor chef de la década en la Copa Culinaria Carozzi. En cada capítulo se mostrarán las vidas de los competidores en torno a la cocina y el público podrá ser testigo de las competencias donde defenderán la permanencia en el programa. En cada episodio habrá un ganador y un eliminado.

DE COPA CULINARIA CAROZZI 2025
n cuanto a este nuevo reto en la pantalla chica, que coincide con su regreso a Canal 13 después de haber liderado Aquí somos todos en 2021, Angélica Castro expresó que “es un honor que me hayan llamado para conducir este proyecto, porque amo la cocina, me encanta cocinar y admiro profundamente a los chefs”.
Ellos realizan un gran trabajo que no siempre se puede ver. Por eso, en este proyecto mostraremos las historias que hay detrás de los profesionales, revelaremos el sacrificio y la exigencia que significa cocinar”, aseguró. a animadora precisó que para ella estar en el proyecto es un regalo, “porque, para mí, cocinar es una pasión y una de mis terapias para relajarme. Es algo que siempre hago con Laura (su hija), nos encanta cocinar y crear nuevas recetas. Siento que la cocina es el lugar de encuentro de una casa, la cocina es el corazón de un hogar”.

Úrsula Corberó anunció que espera a su primer hijo junto al Chino Darín, con quien mantiene una relación desde hace casi 10 años
La actriz española, reconocida por su papel de Tokio en La Casa de Papel, publicó en Instagram una foto donde luce un camisolín blanco sobre un sillón del mismo color. En la imagen aparece arrodillada, con la espalda inclinada hacia atrás y apoyada en el respaldo, mostrando su panza con el bebé en camino.
Además, decidió hacer este gran anuncio con humor ya que, no solo etiquetó al actor argentino con una etiqueta sobre su vientre, sino que comentó: “Esto no es IA (inteligencia artificial)”. Los actores se conocieron en el 2016 durante el rodaje de la serie española La Embajada, donde se flecharon por completo. Hoy, nueve años después, van a traer al mundo a su primer hijo y al primer nieto de Ricardo Darín, quien ha pronunciado su deseo de tener este título pero sin presionar a sus hijos.
¿CÓMO ES LA INTIMIDAD DE ÚRSULA CORBERÓ Y EL CHINO DARÍN?
En una de sus visitas a Argentina el año pasado, estuvo en Sería Increíble (Olga) donde se generó una entrevista más descontracturada y en la que fue consultada por su relación con el Chino Darín: “Llevamos ocho años con el Chino”.
“¿Ya llegó a tirarse u pedo leyendo el diario?”, le consultó sin tapujos Homero Pettinato. Entonces, la española se sinceró: “Chicos, nos tiramos pedos el uno con el otro. Es hermoso tirarse pedos”.
“¿Le avisás?”, reaccionó Nati Jota. Por lo que, la actriz explicó: “No, a veces lo escucha y nos reímos. Tenemos un juego además”.
E n ese momento, reveló de
qué se trata la costumbre que tienen con su pareja al momento de tirarse flatulencias: “Hacemos como que hacen algo y no sabemos que es... hay que ser ocurrente. Siempre tienes que decir algo distinto. Pues tipo ‘ay esa obra de al lado, a ver si termina ya”’.



Un equipo de investigadores de la Escuela de Tecnología Médica de la Pontificia Universidad Católica de Valparaíso (PUCV), compuesto por una académica, dos alumnas de pregrado y dos Alumni, presentó interesantes resultados que sugieren que la obesidad podría favorecer la progresión del cáncer de mama.
El trabajo se realizó con vesículas extracelulares, que son pequeñas nanopartículas liberadas por todas las células del cuerpo que transportan información genética y molecular. Estas se aislaron de la sangre de pacientes con obesidad y de personas con peso normal, para luego tratar a células de cáncer de mama triple negativo en el
A través de la utilización de vesículas aisladas de la sangre de pacientes con y sin obesidad y luego usadas para tratar células cancerígenas, el estudio arrojó una serie de alteraciones que pueden acelerar la enfermedad.
laboratorio.
“A todos los participantes se les extrajo una muestra de sangre desde la cual se aislaron vesículas extracelulares presentes en el plasma. Estas nanopartículas son liberadas de manera natural por todos los tejidos del cuerpo como parte de la comunicación celular”, indicó la académica Alejandra Sandoval, líder del proyecto.
“Estas vesículas transportan ADN, ARN, proteínas y lípidos,
lo que permite que la célula de origen envíe información a otras células y órganos”, precisó la académica.
Tras aislarlas y caracterizarlas mediante microscopía de transmisión electrónica para comprobar su tamaño y forma, fue posible usarlas in vitro para simular parte del ambiente metabólico de personas con obesidad.
Los resultados revelaron que las vesículas extracelulares
provenientes de personas con obesidad generaron cambios en las células cancerígenas que podrían favorecer la progresión del cáncer, como mayor expresión de marcadores inflamatorios tales como citoquinas proinflamatorias, que aumentan en cualquier tejido u órgano donde se produzca una infección o lesión.
“También, el aumento del nivel de expresión de marcadores de transición epitelio mesenquimal. Esto suele implicar que las células pierden características epiteliales y ganan rasgos mesenquimales como mayor movilidad, a menudo asociados con la resistencia a terapias y mayor potencial metastásico. También se encontró una mayor capacidad de migración, lo que facilita la expansión del cáncer y mayor formación de vasos sanguíneos (angiogénesis), que alimentan el crecimiento de los tumores”, explicó Sandoval.
“Este hallazgo refuerza la idea de que no solo la genética del tumor importa, sino también las señales que recibe desde el organismo. El entorno metabólico de un paciente puede ser clave en la evolución del cáncer”, señaló la investigadora.
El estudio incluyó a personas entre 18 y 45 años cuyo Índice de Masa Corporal (IMC) fue evaluado previamente.
El proyecto, adjudicado en 2023 gracias a un fondo de la Sociedad Chilena de Endocrinología y Diabetes, contempla múltiples etapas de investigación, desde estudios in vitro en laboratorio hasta proyecciones hacia modelos preclínicos.
En ese sentido, obtuvo el segundo lugar en la categoría

de trabajos científicos del VII Congreso Chileno de Oncología Médica, lo que refuerza el impacto y proyección de este avance biomédico.
“Este estudio muestra una asociación entre la obesidad y la progresión del cáncer. Un paciente con obesidad podría tener mayor probabilidad de que su enfermedad avance debido a las señales metabólicas y moleculares que circulan en su cuerpo”,
remarcó Sandoval.
EQUIPAMIENTO ESCUELA DE TECNOLOGÍA MÉDICA
La Escuela de Tecnología Médica PUCV dispone de laboratorios equipados, incluyendo una sala de cultivo celular que permite realizar investigaciones in vitro con modelos de cáncer,
Viene de página anterior
probar nuevas drogas y evaluar nuevos biomarcadores.
Para las y los estudiantes que participaron, esta investigación no es solo un trabajo de laboratorio, sino un aporte directo a la salud de las personas, así lo expuso Julia Carreño, estudiante de pregrado de Tecnología Médica PUCV.
“El cáncer suele diagnosticarse tarde y conlleva cambios muy duros en la vida de quienes lo enfrentan. Con esta investigación queremos ir más allá de confirmar que la obesidad es un factor de riesgo, buscamos comprender qué mecanismos específicos activa y cómo podemos intervenirlos. La idea es abrir camino a nuevos enfoques preventivos, por ejemplo, mediante biomarcadores que permitan anticipar o frenar la enfermedad”, indicó.
Por su parte Rosario Salgado expresó que la experiencia de trabajar con el equipamiento de la escuela resultó muy enriquecedora.

“Me permitió aplicar los conocimientos teóricos y comprender de primera mano el funcionamiento de un laboratorio, especialmente en cultivo celular. Su manejo fortaleció mi confianza, impulsó el desarrollo de habilidades técnicas y fomentó una actitud más cuidadosa y responsable, preparándome mejor para el ámbito profesio -
nal”, sostuvo.
Para incentivar la participación estudiantil en proyectos y entregar herramientas a profesionales, la Escuela de Tecnología Médica dicta cada verano un curso intensivo de cultivo celular, en el cual pueden aprender técnicas avanzadas y sentar bases para futuros estudios de interés.

Alimentación saludable y actividad física: Factores que podrían ayudar a mejorar la reserva ovárica en mujeres

Poco se habla de la reserva ovárica. Cada día es más común ver que las mujeres posterguen la llegada de hijos e hijas, por diversos factores: tener un mayor desarrollo profesional, aspectos económicos, educacionales, de salud, entre otros.
“Evaluar la reserva ovárica es importante porque permite a la mujer conocer su potencial reproductivo y así tomar decisiones en relación a la planificación de su futura maternidad”, dice la doctora Abril Salinas Quero, ginecóloga especialista en Medicina Reproductiva, profesora asistente de la Facultad de Medicina de la U. de Chile.
La reserva ovárica se refiere al número de los óvulos en los ovarios de una mujer, por ende, es vital saber esta información
Sigue en página siguiente
“Se refiere al número de óvulos en los ovarios de una mujer”, explica la Doctora Abril Salinas Quero, ginecóloga con especialidad en Medicina Reproductiva y profesora asistente de la Facultad de Medicina de la U. de Chile.

La reserva ovárica es finita y disminuye con el tiempo y la edad.
Viene de página anterior desde jóvenes, dado que lamentablemente no se puede aumentar la cifra. En otras palabras, la cantidad de ovocitos que tenemos está destinada desde que nacemos.
La también jefa del Programa de Fertilización in Vitro (IVF) del Instituto de Investigaciones Materno Infantil (IDIMI) y vicepresidenta de la Sociedad Chilena de Medicina Reproductiva, señala que “lamentablemente la reserva ovárica no se puede aumentar, dado que está destinada desde nuestra vida intrauterina. Y va declinando a medida que vamos desarrollándonos hasta que se termina con la llegada de la menopausia”.
Habitualmente la calidad y cantidad de ovocitos comienza a disminuir a partir de los 30 años, con una caída más marcada después de los 35 años. Y, dice la doctora “ya desde los 40 años la disminución es mucho mayor y acelerada por eso es más difícil conseguir un embarazo exitoso y hay más riesgo de aborto también”.
Asimismo, advierte que algunos factores pueden hacer que la reserva ovárica disminuya en forma más acelerada o prematura en algunas mujeres, “como múltiples cirugías ováricas, recibir tratamientos gonadotóxicos como la quimioterapia o radioterapia por lo cual este grupo de mujeres puede ver comprometida su fertilidad en etapas más tempranas de la vida y deberían recibir una consejería y atención más oportuna”, dice.
Sin embargo, la especialista apunta a que “si mantenemos un estilo de vida saludable podemos mejorar nuestra función ovárica y disminuir el riesgo de una pérdida más acelerada de nuestra reserva ovárica, por eso


recomendamos llevar una dieta nutritiva, realizar actividad física en forma regular, evitar el tabaco y el alcohol”.
La profesora asociada de la Facultad de Medicina, doctora Abril Salinas Quero, explica que en la actualidad hay dos tipos de exámenes que permiten evaluar la reserva ovárica de una mujer.
La hormona antimülleriana AMH: examen de sangre que se puede tomar en cualquier momento de nuestro ciclo menstrual. “No es un examen invasivo más que por la toma de una muestra de sangre, desde este año tiene codificación por Fonasa por lo que está cubierto por los seguros de salud y su costo varía entre clínicas (entre
40 a 80 mil pesos)”, dice la especialista.
Recuento de folículos antrales: o “huevitos” que están esperando ser reclutados para la ovulación en cada ciclo menstrual. Salinas, dice que “esta evaluación se realiza a través de una ecografía ginecológica por vía transvaginal, idealmente entre el tercer y quinto día de nuestro ciclo menstrual. No es un examen costoso”.
Sobre la importancia de tener acceso a este tipo de exámenes, la ginecóloga U. de Chile, afirma que “nos permite a nosotras las mujeres entender mejor nuestra salud reproductiva y así poder tomar decisiones más informadas sobre nuestra planificación familiar”.
Y, agrega que “el hecho que la AMH haya sido incluida en la modalidad Libre Elección de Fonasa es un avance muy importante, ya que facilita la evaluación del estado reproductivo
en un mayor número de mujeres. Aunque lamentablemente aún no se encuentra disponible en gran parte de los servicios públicos”.
CONGELAR NUESTROS ÓVULOS, ¿PUEDE SER UNA ALTERNATIVA?
La respuesta es sí. “Es una opción viable para las mujeres que desean postergar la maternidad. La congelación de óvulos es más efectiva cuando se realiza a edades más tempranas (idealmente antes de los 35 años) debido a la mejor calidad ovocitaria”, señala la ginecóloga.
También advierte que este procedimiento no asegura en un 100% un embarazo en el futuro, pero sí mejora las posibilidades si se busca ser madre a edades más avanzadas.
FACTORES PUEDEN AFECTAR NEGATIVAMENTE LA CALIDAD DE NUESTROS ÓVULOS?
La edad es el principal factor que afecta la calidad de los ovocitos, pero esto no es un factor modificable. “La calidad de los ovocitos se puede ver afectada negativamente por factores como la exposición a toxinas ambientales, hábitos tabáquicos y consumo excesivo de alcohol. La obesidad y sobrepeso también afecta la calidad de los ovocitos”, apunta Salinas. Agrega que algunas condiciones ginecológicas como la endometriosis o lesiones ováricas que conllevan múltiples cirugías ováricas. Y que en aquellas niñas o mujeres sobrevivientes de cáncer que recibieron quimioterapia gonadotóxica o radioterapia pélvica la calidad de los ovocitos también se ve deteriorada.


ARIES
(21 de marzo al 20 de abril)
AMOR: Las cosas van a mejorar en el plano sentimental para solteros/as y comprometidos/as. SALUD: Tenga buen sueño, no pase rabias, así se olvidará de la jaquecas. DINERO: Los mejores éxitos se construyen poco a poco y con mucho esfuerzo. COLOR: Negro. NUMERO: 23.
TAURO
(21 de abril al 20 de mayo)
AMOR: El momento de dar pasos más importantes, deje las dudas de lado y consolide en las cosas. SALUD: Levantarse más temprano para hacer ejercicios le traerá recompensas. DINERO: Salga a buscar trabajo, su presupuesto no da para más. COLOR: Amarillo. NUMERO: 14.
GEMINIS
(21 de mayo al 21 de junio)
AMOR: Haga que afloren esos sentimientos. Si sigue ocultando lo que siente se verá perjudicado/a. SALUD: Haga más ejercicios para disminuir la tensión acumulada en usted. DINERO: No olvide que debe controlar bien sus finanzas. COLOR: Rosado. NÚMERO: 9
CÁNCER
(22 de junio al 22 de julio)
AMOR: El entusiasmo y la pasión no le garantizan un sentimiento profundo. Espera un tiempo. SALUD: Ten cuidado con consumir medicamentos para bajar de peso y menos si te estás auto medicando. DINERO: Cuidado en lo que queda de quincena. COLOR: Celeste. NUMERO: 2.


Jueves 11 de septiembre 2025
LEO
(23 de julio al 22 de agosto)
AMOR: Ese corazón no es inalcanzable como parecía ser, basta con sacar a relucir tus habilidades de conquista. SALUD: No consuma muchas cosas picantes en especial si padece de úlceras. DINERO: Viene una etapa que no la espera, tiene que saber enfrentarla. COLOR: Rojo. NUMERO: 28.
VIRGO
(23 de agosto al 22 de septiembre)
AMOR: Debe volver a la realidad y dejar de pensar que las cosas serán como los cuentos de hadas. SALUD: Tengo mucho cuidado con los estados depresivos. DINERO: Tendrá algo más de dinero, pero no lo malgaste. Distribuya mejor sus recursos. COLOR: Granate. NUMERO: 7.
LIBRA
(23 de septiembre al 22 de octubre)
AMOR: Debe planificar sus movimientos en sus afanes de conquista. Pero debe tener mucho tino SALUD: No coma mucho antes de ir a dormir, esto puede traerle un problema de insomnio. DINERO: Para tener éxito debe proponérselo. COLOR: Marengo. NUMERO: 18.
ESCORPIÓN
(23 de octubre al 22 de noviembre)
SAGITARIO
(23 de noviembre al 20 de diciembre)
AMOR: Ahora debe levantarse y ponerle el hombro a las cosas, pronto brillara el sol. SALUD: Tómese un momento para alejarse de las presiones del día a día. DINERO: No se endeude en cosas que después no podrá cumplir. COLOR: Morado. NÚMERO: 11.
CAPRICORNIO
(21 de diciembre al 20 de enero)
AMOR: No debe permitir que otros se entrometan tanto en tu toma de decisiones. SALUD: Coma a las horas que le correspondan. DINERO: Le irá muy bien encontrará trabajo más luego de lo pensado, vea los anuncios del periódico. COLOR: Naranjo. NÚMERO: 33.
ACUARIO
(21 de enero al 19 de febrero)
AMOR: No ha valorado las virtudes de su pareja. Sepa reconocer lo que tiene y no pase quejándose. SALUD: Solo necesita un giro en su vida. DINERO: Procure mantener distancia de cualquier conflicto que haya en su lugar de trabajo. COLOR: Azul. NÚMERO: 26.
PISCIS
(20 de febrero al 20 de marzo)
AMOR: Las discusiones son normales de la vida de pareja pero no deben salirse de control. SALUD: Cuide su sistema nervioso, evite caer en estados de tensión por este día. DINERO: Con el dinero que tiene ahorrado podrá mejorar su casa. COLOR: Lila. NÚMERO: 10. HOROSCOPO
AMOR: La vida tiene muchas vueltas como para que te deprimas por aún no haber hallado el amor. SALUD: A veces no es necesario darle mucho realce a las molestias, pronto pasarán. DINERO: Le está yendo bien, pero cuidado con confiarse más de la cuenta. COLOR: Fucsia. NUMERO: 15.

Dirección: Eduardo Castillo Velasco 3400, Ñuñoa, metro Chile-España, Santiago. Fono: +56 9 5775 8508
PROVINCIAS DE QUILLOTA Y PETORCA
HONDA ACCORD 1994, para enchular o vendo para repuestos, buen estado, $300.000. Fono 983938445.
NISSAN NEW X-Trail sense, 2,5, automática, año 2018, 115.000 kms., excelente estado, $11.490.000. Fono 990357095.
CHEVROLET SPARK LT 2013, 1.0, dirección hidráulica, llantas, excelente estado, papeles al día, $2.850.000 999224119.
FORD FIESTA, año 2018, full equipo, 120.000 kilómetros, impecable, $6.750.000. Fono +56967568041.
PEUGEOT COMPAC 207, hatchback, 2011, impecable, $4.590.000. Toyota Yaris, sedán, 2010, $4.490.000. Chery Tiggo 2, 2022, único dueño, $9.490.000. WhatsApp Fono +569-94998176 Cuneo Autos.
TOYOTA YARIS, 2008, hatchback, $ 3.250.000. MG3, 2014, bicolor, $5.650.000. Chevrolet Chevette, 1990, impecable, $1.550.000. WhatsApp Fono +56 9-94998176 Cuneo Autos.
GREAT WALL Safe 2.2cc, station wagon, año 2008, doble cabina, documentos al día, impecable, $5.800.000. Fono 953933965.
CHEVROLET TRAILBLAZER, 2019, único dueño, diésel, automática $ 14.990.000. Nissan Terrano, 2010, doble cabina, bencinera, $4.590.000. Citroën Xsara, diésel, 2002, station wagon, $2.790.000. Recibimos vehículo. WhatsApp Fono +56 9-94998176 Cuneo Autos.
FORD RANGER, doble cabina, 1999, motor 2.5, bencinera, buen estado, papeles al día, $3.000.000, 999224119.
FURGÓN CHEVROLET N-300, año 2012, 110.000 kms., buen estado, documentación al día, $3.500.000. Contacto +56926365171 ó +56966014479.
ATENCIÓN FURGÓN Suzuki Mastervan, pasajeros año 2002, 1.3cc., estado general vehículo ok. Valor $4.450.000 conversable, oportunidad. Cel 996926518 La Calera.
LA CALERA, arriendo condominio Ravello, lindo departamento 3 dormitorios, estacionamiento, guardias, canón $450.000. Corredor +56983456695.
LA CRUZ, arriendo en condominio Las Palmas, departamento 3 dormitorios, estacionamiento, paradero 14. Corredor +56983456695.
ARRIENDO CASA, 2 pisos en El Retoño, 2 dormitorios, 1 baño, estacionamiento, excelente barrio a pasos de supermercados y centros comerciales. $330.000 +garantía. +56998143249.
ARRIENDO DEPARTAMENTO
EL MELÓN, casa 7 dormitorios, 2 baños, patio, solo empresas $1.200.000 amoblada. Propiedades Santa Irma fono 993696944.
LA CALERA Artificio, casa 3 dormitorios, Arboleda, $390.000. Propiedades Santa Irma fono 993696944.
QUILLOTA, CASA 3 dormitorios, Jardines del Valle Norte, a dos cuadras de Hospital Biprovincial, $430.000. Propiedades Santa Irma fono 993696944.
VENDO TAXI Ejecutivo Nissan Versa, año 2019, papeles al día, con cupo, $17.000.000 conversable, 942967034.
ARRIENDO DEPARTAMENTO
Condominio Libertadores, Quillota, 3 dormitorios, 2 baños, estacionamiento, $360.000 gastos comunes incluidos. F:+56995574886.
ARRIENDO DEPARTAMENTO, 3 dormitorios, living comedor, baño. Condominio Los Lúcumos, Quillota. Contacto WhatsApp 978518449.
ARRIENDO PIEZA centro La Calera Lizasoain 584,a pasos del rodoviario. Fono 983938445.
LA CALERA, arriendo departamentos amoblados, empresas y particulares, 4 y 3 habitaciones, 2 baños, estacionamiento privado. Fono 991640273.
ARRIENDO DEPARTAMENTO
Condominio Nemesio Antúnez, Quillota, $350.000 mas mes de garantía, gastos comunes incluidos, 981936903.
ARRIENDO DEPARTAMENTO tercer piso, paradero 27, Calera, $300.000 mas garantía, acepto subsidio arriendo. Fono 963410026.
Villa General Mackenna con Pudeto, Quillota. 3 dormitorios c/closet, 1 baño, cocina amoblada, reacondicionado completo, lavadero, estacionamiento común, ventanales de aluminio, $350.000. Contacto 976152162.
DEPARTAMENTO
CONDOMINIO Altos de Merced, Torre 1, 3 dormitorios, 1 baño, estacionamiento, closet. $370.000 gastos incluidos. Estado impecable. Centro de Quillota. Fono 955367408.
HABITACIONES AMOBLADAS a empresas, baño privado, estacionamiento, persona sola, internet, lavadora, secadora, cocina, +56982654460. Quillota
QUILLOTA, CASA, Reyes Católicos, 4 dormitorios, $310.000. Departamento Avda. Valparaíso frente HSM, 3 dormitorios $275.000. Fono: 923730990.
ARRIENDO CASA
condominio Villa Turín La Cruz. 3 dormitorios, 1 baño, estacionamiento, conserje, $380.000, acreditar contrato, renta y dicom. Contacto 993825900.
DEPARTAMENTO
CONDOMINIO Alcalá, paradero 12 La Cruz, tercer piso, estacionamiento 3 dormitorios, 2 baños, cocina amoblada, terraza. Pasos locomoción, $430.000 incluye gastos comunes. Corredora +56967397644.
SE ARRIENDA Amplio local comercial ubicado en La Calera ( ex Nightclub San Carlos). Interesados llamar al 982890531.
VENDO CASA población Antumapu, Quillota. 5 dormitorios, 2 baños, living comedor, cocina amplia, estacionamiento. 976424671.
QUILLOTA. EXCELENTE casa 2 pisos, 3 dormitorios, 3 baños, bodega, pieza estudio, logia, garage, amplio patio, frutales. Saneada. $240.000.000 su dueña. Condominio Los Arrayanes. 956572230.
VENDO CASA esquina ampliada. Población Beatita Benavides, Quillota. 3 dormitorios, 1 baño. Contacto 939367276.
CASA POBLACIÓN Independencia Limache, pasos locomoción, cerca supermercados, colegios, 4 dormitorios, 2 baños. cocina amplia, $55.000.000 conversable. Corredora +56967397644.
LINDOS DEPARTAMENTOS, primer piso, 3 dormitorios, 2 baños, estacionamiento, panel solar, cocina amoblada, ubicado a 5 cuadras Plaza Quillota. $69.000.000. Corredora +56967397644.
HIJUELAS OCOA, parcela 5.000 metros cuadrados, derechos de aguas inscritos $65 millones. Propiedades Santa Irma fono 993696944.
La mejor oferta está en los avisos económicos de EL OBSERVADOR

PROPIEDADES LAGUNA
Prat 213 Oficina 2 FONO: 94322502-2311419
Quillota
VENTAS: $75.000.000 Sendero casa esquina 2 dormitorios. $185.000.000 La Calera, buen sector, 653mt2, frutales. $750.000.000 casa y galpón, 400mt2 central ARRIENDO:
$480.000 departamento nuevo 5ºpiso ; $400.000 departamento central 3 dormitorios.
AGRÍCOLAS Y FORESTALES 300
PROVINCIAS DE QUILLOTA Y PETORCA
VENDO POTRILLOS, chancho grande, 5 chanchos medianos, 1 ternero de 1 año. Contacto 957975910 Limache.
SERVICIOS EN GENERAL 550
PROVINCIAS DE QUILLOTA Y PETORCA
DIVORCIO. FACILIDADES de pago. Quillota-Abogados. Fono +56 991264805 Email camila. maldo.c@gmail.com
AMARANTA TAROT, ven a descubrir que depara tu destino. Martes y viernes de 11:00 a 20:30 horas, horario continuado. Freire, 1025. 995400565.
La mejor oferta está en los avisos económicos de EL OBSERVADOR
Empleos
IMPORTANTE EMPRESA agrícola de Quillota e Hijuelas, necesita: Matrimonio para labores de portería en predio agrícola. Se entrega casa. Enviar antecedentes curriculares con pretensiones de renta a reclutamientoagricola76@ gmail.com
IMPORTANTE EMPRESA agrícola de Quillota e Hijuelas, necesita: Regador con experiencia en riego tecnificado de paltos. Enviar antecedentes curriculares con pretensiones de renta a reclutamientoagricola76@ gmail.com.
IMPORTANTE EMPRESA agrícola de Quillota e Hijuelas, necesita: Trabajador agrícola con experiencia en manejo de tractor (licencia clase D). Enviar antecedentes curriculares con pretensiones de renta a reclutamientoagricola76@ gmail.com
EMPRESA AGRÍCOLA de Quillota busca Ayudante de Bodega. Requisitos: Enseñanza media completa, Técnico Agrícola (no excluyente), curso de manejo y uso de Plaguicidas (no excluyente). Licencia de conducir clase B(clase D opcional). Sueldo acorde al mercado. Estabilidad Laboral. Se requiere persona responsable, ordenada y proactiva. Principales funciones: apoyo en bodega, control, orden y entrega de insumos y/o herramientas agrícolas. Interesados enviar
curriculum al correo elmolino@ agricolaelmolino.cl indicando en el asunto “Ayudante de Bodega”.
NECESITAS AUMENTAR tus ingresos. Te invito a vender nuestros productos por catálogos. Esika, Lbel, Czone. Llama fono WhatsApp +56973980423.
SE NECESITA trabajador para taller de desabolladura y pintura en Quillota. Reales interesados enviar Currículum y pretensiones de sueldo a automotrizbq@gmail.com


Empleos buscan 620
PROVINCIAS DE QUILLOTA Y PETORCA
PROVINCIAS DE QUILLOTA Y PETORCA
SE NECESITA Administrativo contable para formar parte de nuestro equipo, en donde contamos con un grato ambiente laboral, para esto debes contar con los siguientes requisitos: experiencia en Administración Contable y financiera, manejo de normativa tributaria y laboral, manejo de software contable y de remuneración. Se ofrece: Sueldo acorde al mercado, buen ambiente de trabajo, jornada laboral de lunes a viernes. Interesados enviar CV y certificado de Titulo actualizado a: consultoraspafilippi@gmail.com
SE NECESITA trabajador agrícola para trabajos en paltos, riego, poda, herbicida y que maneje tractor. incluye casa sueldo $600.000 más imposiciones. 992292439992392941.
SE NECESITAN peonetas para trabajar en descarga de cementos. Sueldo líquido a pagar 600 mil pesos. Horario lunes a viernes y sábado medio día. Favor comunicarse al siguiente número. Eduardo Hidalgo 994962409. Benjamín Castro 942899059
SE NECESITAN Profesores de: Lenguaje, Matemáticas, Educación General Básica, Música y Educación Física. Enviar CV al correo: admisionliceodelacruz@gmail. com
COLEGIO QUILLOTA Terranova, busca los mejores profesionales de la zona para su base de datos y planta docente 2026. Enviar CV al correo rrhh@ colegioquillotaterranova.cl especificando el cargo al que postula. Necesitamos docentes de Educación Diferencial, Matemáticas, Ed. Básica, Ed. Parvularía; Psicóloga (experta en psicometrías y convivencia escolar) y Técnicos en Ed. diferencial.
SE OFRECE señorita, para cuidado anciano, labores de aseo, ayudante de cocina, disponibilidad inmediata. 996762391.
700
OTROS AVISOS
PROVINCIAS DE QUILLOTA Y PETORCA
VENDO SEPULTURA parque Quillota, cuatro capacidades. Comunicarse a los teléfonos 944375917 o al 967681084
La mejor oferta está en los avisos económicos de EL OBSERVADOR
PROVINCIAS DE QUILLOTA Y PETORCA
MADURITA VENEZOLANA, rica, exquisita y muy complaciente, trato de novia. Comunícate al 975548427.
VENEZOLANA RICA, complaciente, trato de novia, 975533156.
VALERIA LINDA colombiana en promoción, ardiente scort. 927316772
ARDIENTE, CUARENTONA, voluptuosa, blanquita, discreta, motel o domicilios 24/7 desde $10.000. ±56968567092.
MADURA COMPLACIENTE, rica y sensual, trato de novios. Fono: 942437341.
VENEZOLANA RICA exquisita, 30 años, complaciente. Contacto 971223868.


Viene de página anterior
EXTRACTO NOTIFICACIÓN POR AVISOS. Juzgado de Familia de La Ligua. En causa RIT C-462-2023, sobre “ALIMENTOS” y “CUIDADO PERSONAL”, caratulado “DÍAZ/ ROMÁN”, a folio 94 se ha ordenado notificar a la demandada MERY DEL CARMEN ROMÁN ROMÁN, RUN Nº15057443-9, mediante aviso redactado por ministra de fe, de resolución que reprograma audiencia de juicio, fijándose para el 06 de octubre de 2025, a las 08:30 horas, sala 2, DE FORMA PRESENCIAL , ante el Juzgado de Familia de La Ligua, ubicado en Vicuña Mackenna Nº 268, La Ligua, pudiendo comparecer en forma telemática a través de la plataforma zoom, previa autorización del tribunal. Notifíquese a la demandada, de conformidad con el artículo 23 inciso cuarto de la Ley 19.968 mediante la publicación de un aviso en un diario de circulación nacional por estimarse que constituye un medio idóneo que garantiza la debida información del notificado para el ejercicio de sus derechos. Proveyó Juez (T) del Juzgado de Familia de La Ligua. La Ligua, once de julio de dos mil veinticinco. Carolina Mercado Ramírez Jefa de Unidad – Ministra de Fe (S) Juzgado de Familia de Ligua. EXTRACTO NOTIFICACIÓN POR AVISOS. Juzgado de Familia de La Ligua. En causa RIT C-318-2023, sobre “ALIMENTOS”, caratulado “DELGADO/OBANDO”, a folio 106 se ha ordenado notificar a la demandada GABRIEL ALEJANDRO OBANDO BERNAL, RUN Nº 16825328-1, mediante aviso redactado por ministra de fe, de resolución que reprograma audiencia de juicio, fijándose para el 09 de octubre de 2025, a las 12:45 horas,
sala 2 DE FORMA PRESENCIAL , ante el Juzgado de Familia de La Ligua, ubicado en Vicuña Mackenna Nº 268, La Ligua, pudiendo comparecer en forma telemática a través de la plataforma zoom, previa autorización del tribunal. Notifíquese a la demandada, por a lo menos un aviso, en el mismo Diario por el cual se efectuaron las publicaciones en el historial de la presente causa, al tenor del artículo 54 de Código de Procedimiento Civil. Para más información, consulte Portal PJUD
A través del enlace: https://oficinajudicialvirtual.pjud.cl/home/, ingresando clave única y RUT. Proveyó y firmó digitalmente, Juez del Juzgado de Familia La Ligua. La Ligua, nueve de julio de dos mil veinticinco. Carolina Mercado Ramírez Jefa de Unidad – Ministra de Fe (S) Juzgado de Familia de Ligua. EXTRACTO NOTIFICACI Ó N POR AVISOS. Juzgado de Familia de Ligua. En causa RIT C-224-2023, sobre “CUIDADO PERSONAL CON

EL NIÑO” y “ALIMENTOS”, caratulado “PIZARRO/ENCINA”, a folio 104 se ha ordenado notificar a la demandada a doña CONSTANZA DE LAS MERCEDES ENCINA BECERRA, RUN Nº 15368278-K, mediante aviso redactado por ministra de fe, de resolución que cita a las partes a pericia psicológica en Servicio Médico Legal Valparaíso (Orella 911, Valparaíso): CONSTANZA DE LAS MERCEDES ENCINA BECERRA, RUN Nº15368278-K con fecha para el día 14 de octubre de 2025 a las 10:00 horas; NNA C.A.P.E. RUN Nº 23395458-6 con fecha para el día 08 de octubre de 2025; NNA J.T.E.E. RUN Nº 24618288-4 con fecha para el día 13 de octubre de
2025. Notifíquese a la demandada, de conformidad con el artículo 23 inciso cuarto de la Ley 19.968, mediante la publicación de un aviso en un diario de circulación nacional por estimarse que constituye un medio idóneo que garantiza la debida información del notificado para el adecuado ejercicio de sus derechos. La Ligua, treinta de julio de dos mil veinticinco. Carolina Mercado Ramírez Jefa de Unidad – Ministra de Fe (S) Juzgado de Familia de Ligua.
EXTRACTO NOTIFICACIÓN POR AVISOS Juzgado de Familia de La Ligua. En causa RIT C-160-2024,
Continúa en página siguiente

Viene de página anterior
sobre “Cuidado Personal del Niño, Declaración”, caratulada “ VERA/ RIVAS ”, demandante EDGAR MANUEL VERA FIGUEROA, RUN Nº 11830062-9, demandado BRENDA ARACELLI RIVAS MALLEGA , RUN Nº 22601903-0, a folio 53 se ha ordenado notificar a la parte demandada, mediante aviso redactado por ministra de fe, de los siguientes antecedentes: Demanda presentada con fecha 07 de mayo de 2024, por la que se solicita el cuidado personal de NNA K.A.V.R. RUN Nº 27593332-5; resolución de 14 de mayo de 2024 que da curso a la demanda; y resolución de 29 de julio de 2025, que cita a audiencia preparatoria para el día 10 de octubre de 2025, a las 08:30 horas, en Sala 2 , a celebrarse de forma presencial, bajo apercibimiento de lo dispuesto en el artículo 59 de la Ley Nº 19.968. La audiencia se celebrará en dependencias de este tribunal, ubicado en Vicuña Mackenna Nº 268, La Ligua, pudiendo comparecer en forma telemática a través de la plataforma zoom, previa autorización del tribunal. Notifíquese a la demandada según lo dispuesto en el artículo 54 del Código de Procedimiento Civil, esto es, tres publicaciones de avisos en un diario de circulación, a lo menos, regional, para tales efectos, se designa el Diario El Mercurio de Valparaíso, sin perjuicio de la notificación de un aviso en el Diario Oficial en las condiciones y oportunidades previstas por la norma. Para más información, consulte Portal PJUD A través del enlace: https://oficinajudicialvirtual.pjud.cl/home/, utilizando clave única y RUT. La Ligua, veinte de agosto de dos mil veinti -
cinco. Carolina Mercado Ramírez Jefa de Unidad – Ministra de Fe (S) Juzgado de Familia de Ligua. REMATE: ANTE Décimo Primero Juzgado Civil de Santiago, Huérfanos Nº1409, piso 3, el día 15 de octubre de 2025 o día hábil siguiente en caso de suspenderse por motivos ajenos al tribunal, a las 13:00 horas, se rematará el lote o parcela Nº11, que resultó de la subdivisión del resto de la zona o lote denominado El Cuarzo, comuna de Hijuelas, Región Valparaíso, inscrita a fojas 2.637 Nº2.243 del registro de propiedad del Conservador de Bienes Raíces de La Calera, año 2015. Mínimo subasta será: $707.636.- Pago contado dentro de quinto día hábil de efectuado el remate. Interesados rendir caución suficiente por medio vale vista nominativo a la orden del tribunal, por el equivalente al 10% del precio mínimo, el que deberá presentarse en la secretaria del tribunal al momento de efectuarse el llamado a remate, junto con fotocopia de la cédula de identidad del tomador. Demás bases y antecedentes causa rol Nº C-13747-2023. Caratula “Reserva Ecológica Oasis de La Campana con Espinoza”. El Secretario.
EXTRACTO. 1 º JUZGADO DE LETRAS DE QUILLOTA , concedió por resolución de fecha 19 de agosto del año 2025, posesión efectiva testada de ALFREDO LUIS VERGARA FLORES, en favor de doña JUANA ESTER SOTO MENDEZ, como heredera testamentaria a título universal de todos sus bienes. Secretaria. AGRÍCOLA PURUTÚN LTDA. Informa por este medio a don Bernardino Zapata Traro, que su finiquito está a su disposición para ser retirado en nuestra oficina ubicada en Panamericana Norte Km120, sin número Nogales o contactase al correo recursoshumanos@bhnchile.cl
REMATE: CUARTO JUZGADO CIVIL DE VALPARAISO, CAUSA ROL 1886-2014, Pagare, cobro de, BANCO DEL ESTADO con CEPEDA SAAVEDRA RAFAEL ANTONY, fijó audiencia del día 25 DE SEPTIEMBRE DE 2025 a las 09:30 HORAS, para subastar propiedad ubicada en la COMUNA DE VALPARAISO, Local Comercial Nº 6, ubicado en calle José Serey Nº 252 rol interno de la Corvi Nº 340 de la Población Quebrada Verde Segunda, plano agregado con el N º 1286 en el Registro de Documentos del año 1963 del Conservador de Bienes Raíces de Valparaíso, inscrita a fojas 131 vuelta, número 225, del Registro de Propiedad del año 2004 del Conservador de Bienes Raíces de Valparaíso. MINIMO SUBASTA $21.931.584.- Remate se llevará a efecto se llevar a efecto por la plataforma á ZOOM, en el link https://zoom.us/j/3802621329. Todo postor excepto ejecutante, deberá rendir caución diez por ciento del mínimo. La caución fijada deberá ser consignada en la cuenta corriente del Tribunal, mediante depósito judicial o cupón de pago (NO TRANSFERENCIA ELECTRÓNICA), bajo los siguientes datos: Cuarto Juzgado Civil de
Valparaíso, Cuenta Corriente Banco del Estado N º 23900213638, R.U.T. 60.305.002-9 y rol de la causa. Precio se pagará al contado dentro de 5to día hábil desde fecha subasta. Propiedad se subasta ad-corpus, en el estado en que actualmente se encuentra. Escritura adjudicación debe suscribirse dentro plazo de 30 días hábiles contados desde la fecha de la resolución que ordenó extender la escritura pública de adjudicación en remate. Todos los gastos, impuestos señalados en bases, de cargo exclusivo subastador quien debe fijar domicilio urbano. Demás antecedentes en Secretaría del tribunal. Secretaria (S).


